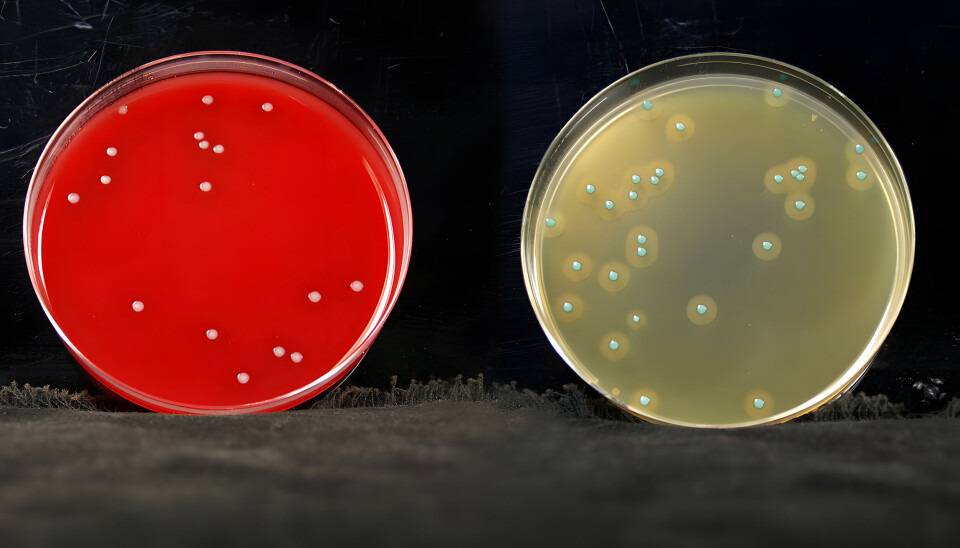

Økt oppmerksomhet på Listeria i laks og ørret
Det er sterke indikasjoner på at røkte fiskeprodukter og råvarer til slike kan være årsak til mange og langvarige listerioseutbrudd. Kan det virkelig stemme? Hva har skjedd? Er det en ny situasjon? Er det vårt problem, dvs. Norges eller næringens?
I en fagartikkel i siste nummer av Norsk Fiskeoppdrett, fra det kanskje fremste fagmiljøet i Norge på Listeria, Veterinærinstituttet, ser man dypere på disse problemstillingene.
Artikkelen er ført i pennen av Taran Skjerdal, som er forsker i matbakteriologi på VI med spesiell referansefunksjon for Listeria i mat.
- Jeg har snakket med mange aktører om Listeria de siste månedene, både media, myndigheter, Mattilsynet, forskerkolleger, EFSA og næringsaktører. Mange er overrasket over funnene som er gjort, mens andre mener at det ikke er noe nytt. Mitt inntrykk, fra jobben som forsker i matbakteriologi på Veterinærinstituttet med spesielt ansvar for referansefunksjonen for Listeria i mat, er at det er interessante forskjeller på hvordan situasjonen oppfattes, skriver Skjerdal.
Hun påpeker at noen er overrasket fordi de ikke har forestilt seg at det kan være så store funn uten at konsekvensene for human helse vektlegges sterkere.
- De som er mindre overrasket, legger vekt på at Listeria kan finnes overalt, at det ikke er nulltoleranse for bakterien i mat, at den ikke er meldepliktig, og at de fleste mennesker tåler å få i seg en del Listeria uten å bli syke. Et mellomsyn er at med så høy forekomst som er funnet, og med nylige utbrudd i to land, er det rimelig å anta human listeriose i en del tilfeller spores tilbake til røkte fiskeprodukter og råvarer for slike, skriver hun.
Listeria monocytogenes er en bakterie som kan finnes overalt og er vanskelig å bli kvitt når den har etablert seg i produksjonsmiljøet. Det fleste sykdomstilfeller av listeriose hos mennesker er matbårne.
- En årsak til at det ikke er flere listeriosetilfeller er at sykdom vanligvis oppstår når konsentrasjonen av bakterier er høy. Dødeligheten av listeriose er ca. 20 % og sykdommen gir langvarige sykehusopphold også for de som overlever, skriver hun.
Gravide og deres foster, eldre, barn og de med nedsatt immunforsvar er spesielt utsatt. Denne gruppen advares mot å spise risikoprodukter for å unngå alvorlige konsekvenser som abort, alvorlig sykdom, komplikasjoner med andre sykdommer og dødsfall.
- Alvorlighetsgraden av sykdommen gjør at Listeria monocytogenes regnes i «topp 5» gruppen av fryktede smittestoffer. Internasjonale myndigheter og forskere søker etter årsakssammenhenger og måter å redusere antallet sykdomstilfeller på. Disse skal vi komme tilbake til, men først en «egenvurdering» av om det virkelig kan stemme at laks og ørret kan være årsak til flere sykdomstilfeller enn før, om det bare oppdages flere tilfeller enn før, og hvor årsakene i så fall ligger. Dette kan gjøres med risikoanalyse etter de samme prinsippene som i offentlige utredninger, men på en forenklet måte, skriver Skjerdal.